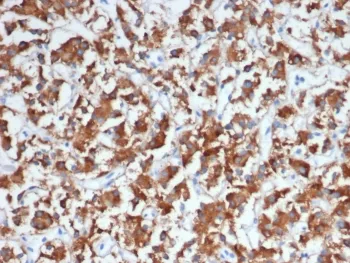
DBH Antibody / Dopamine beta Hydroxylase - image 1

DBH Antibody / Dopamine beta Hydroxylase
CAT:
800-V5313-20UG
Size:
20 µg
For Laboratory Research Only. Not for Clinical or Personal Use.
Price:
Ask
- Availability: 24/48H Stock Items & 2 to 6 Weeks non Stock Items.
- Dry Ice Shipment: No

DBH Antibody / Dopamine beta Hydroxylase
Description:
Dopamine beta-hydroxylase (DBH) catalyzes the conversion of dopamine to noradrenaline in the biosynthesis of catecholamines. DBH is selectively expressed in noradrenergic and adrenergic neurons, as well as in neuroendocrine cells, and it serves as a specific protein marker for noradrenergic processes. The active form of DBH is a homotetramer, which is found in the lumen of synaptic vesicles of corresponding nerve cells, where it localizes to both the membrane and cytosol. DBH is induced by nerve growth factor and Insulin growth factor-1 and is regulated by intracellular second messengers protein kinase A, cyclic AMP, diacyl glycerol and Ca2+. Expression of DBH is transcriptionally mediated by Sp1, CREB and AP-1 proteins including c-Fos, c-Jun and JunD.UniProt:
P09172Host:
MouseImmunogen:
A recombinant partial protein sequence (within amino acids 200-400) from the human protein was used as the immunogen for the DBH antibody.Clonality:
MonoclonalIsotype:
IgG2a κApplications:
IHC-PFormat:
PurifiedBuffer:
0.2 mg/ml in 1X PBS with 0.1 mg/ml BSA (US sourced), 0.05% sodium azideReconstitution:
Aliquot the DBH antibody and store frozen at -20oC or colder. Avoid repeated freeze-thaw cycles.Limitations:
This DBH antibody is available for research use only.CAS Number:
9007-83-4